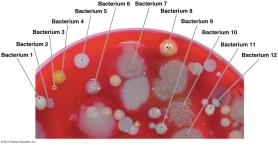
Serological test results

BackA Brief History and Classification of Microbiology
Study Guide - Smart Notes
Tailored notes based on your materials, expanded with key definitions, examples, and context.
Introduction to Microbiology
Microbiology is the study of microorganisms, which are organisms too small to be seen with the naked eye. This field explores the diversity, structure, function, and classification of microbes, as well as their roles in health, disease, and the environment.
Major Classes of Microorganisms
Viruses
Viruses are small infectious agents that can replicate only inside the living cells of organisms. They are unique in that they infect a wide range of hosts, including animals, plants, and bacteria.
Structure: Composed of genetic material (DNA or RNA) surrounded by a protein coat.
Replication: Obligate intracellular parasites; require host machinery for reproduction.
Examples: Influenza virus, Ebola virus, Canine parvovirus.

Algae
Algae are unicellular or multicellular, photosynthetic organisms that are not necessarily green. They have simple reproductive structures and are categorized based on pigmentation, storage products, and cell wall composition.
Habitat: Mostly aquatic environments.
Importance: Primary producers in aquatic ecosystems.

Fungi
Fungi are eukaryotic organisms that obtain energy from other organisms (chemotrophs) and possess cell walls. They are classified as molds (multicellular, with hyphae and spores) or yeasts (unicellular, reproduce by budding).
Molds: Multicellular, filamentous, reproduce by sexual and asexual spores.
Yeasts: Unicellular, reproduce asexually by budding; some produce sexual spores.

Protozoa
Protozoa are single-celled eukaryotes similar to animals in cell structure and nutrition. They typically live in water or as parasites in animals, and most reproduce asexually.
Life Stages: Trophozoite (active), cyst (dormant).
Motility: Pseudopodia, cilia, or flagella.

Prokaryotes (Bacteria and Archaea)
Prokaryotes are unicellular organisms lacking a nucleus. They are smaller than eukaryotes and reproduce asexually. They are found in diverse environments, including extreme conditions.
Bacteria: Cell walls contain peptidoglycan; some are pathogenic, most are harmless or beneficial.
Archaea: Cell walls lack peptidoglycan; often extremophiles (high heat, salt, or pressure).

A Brief History of Microbiology
Era of Speculation
Before the discovery of microorganisms, humans interacted with them unknowingly through food production (bread, wine) and disease. Early societies developed agriculture and animal domestication, leading to sedentary lifestyles and increased disease transmission.

Understanding Biological Organisms
Early studies focused on visible organisms. Key characteristics of life include growth, reproduction, response to environment, movement, metabolism, and organized structure. The theory of spontaneous generation was proposed to explain the origin of small organisms.

Theory of Spontaneous Generation
Originating with Greek philosophers like Aristotle, spontaneous generation was the belief that living organisms could arise from nonliving matter. This idea persisted for centuries, especially for small life forms like flies and fleas.

Early Connections: Environment and Disease
Ancient civilizations such as those in Pakistan/India and Rome made early connections between environment and disease, leading to innovations like aqueducts, sewers, and quarantines. However, the link between microbes and disease was not established due to the inability to see microorganisms.

Discovery of Microorganisms
Antoni van Leeuwenhoek (mid-17th century) was the first to observe microorganisms using simple microscopes. He described 'animalcules' (microbes) in water, laying the foundation for microbiology.

Classification of Microorganisms
Early Taxonomy and Linnaeus
Carolus Linnaeus developed a hierarchical system for classifying organisms, introducing binomial nomenclature (Genus species). Microorganisms were grouped into categories such as small animals, fungi, protozoa, algae, and prokaryotes.
Genus: Capitalized, noun
species: Lowercase, adjective
Both italicized or underlined (e.g., Staphylococcus aureus)

Modern Taxonomy and Domains
Modern classification aims to understand evolutionary relationships. Carl Woese (1980s) used rRNA sequences to propose three domains: Bacteria, Archaea, and Eukarya.
Bacteria: True bacteria, peptidoglycan cell walls
Archaea: Extremophiles, unique cell wall polymers
Eukarya: Organisms with nuclei and organelles

Modern Classification of Prokaryotes
Prokaryotes are classified using multiple criteria:
Macroscopic morphology (colony appearance)
Microscopic morphology (cell shape)
Nucleic acid techniques (G+C content, DNA/RNA analysis)
Physiological/biochemical characteristics
Serological analysis (antibody/antigen reactions)
The Golden Age of Microbiology
Key Questions
During the late 19th and early 20th centuries, scientists addressed fundamental questions:
Is spontaneous generation possible?
What causes fermentation?
What causes disease?
How can infection and disease be prevented?
Experiments on Spontaneous Generation
Experiments by Redi, Needham, Spallanzani, and Pasteur tested the validity of spontaneous generation. Pasteur's swan-neck flask experiment definitively disproved spontaneous generation for microorganisms.

Fermentation and the Scientific Method
Pasteur's experiments demonstrated that living organisms (yeasts and bacteria) cause fermentation, not air or spontaneous processes. This led to the development of the scientific method in microbiology.

Pasteurization
Pasteur developed pasteurization, a process of heating liquids to kill harmful microbes, which helped prevent spoilage and disease.

Germ Theory of Disease and Koch's Postulates
Germ Theory of Disease
Louis Pasteur proposed that specific microorganisms cause specific diseases. Robert Koch established experimental criteria (Koch's postulates) to link microbes to diseases.
Agent must be found in every case of the disease and absent from healthy hosts.
Agent must be isolated and grown outside the host.
Agent must cause the same disease when introduced into a healthy host.
Agent must be reisolated from the newly diseased host.

Limitations of Koch's Postulates
Some pathogens cannot be cultured outside the host.
Some diseases are caused by multiple organisms (synergy).
No animal model exists for some human diseases.
Viral pathogens often do not fit the postulates.

Disease Prevention (1800-1950)
Key figures in disease prevention:
Ignaz Semmelweis: Advocated handwashing to reduce childbirth mortality.
Joseph Lister: Introduced antisepsis in healthcare.
Florence Nightingale: Promoted cleanliness in nursing.
Edward Jenner: Developed the first vaccine (smallpox).
John Snow: Pioneered epidemiology.
Alexander Fleming: Discovered antibiotics (penicillin).